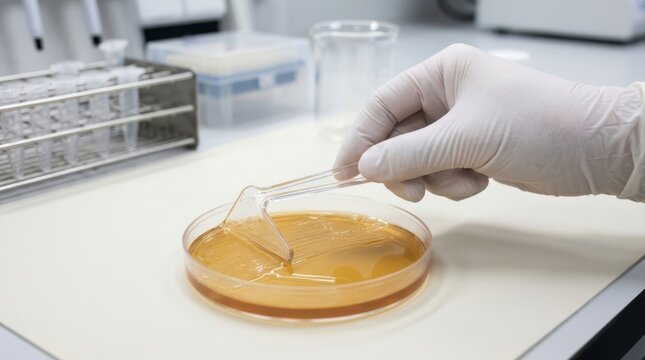
Scientist using a spreader to streak bacteria on an agar petri dish

Бесплатная пробная версия: 10 изображений Stock и ИИ-инструменты для редактирования
Бесплатная пробная версия: 10 изображений Stock и ИИ-инструменты для редактирования
Добавлены новые фильтры
Сортировать по
Попробуйте также:
spreader в категории «Изображения»,
spreader в категории видео,
spreader в категории Премиум
Выберите свой регион
При выборе региона может измениться язык и рекламный контент, отображаемый на веб-сайте Adobe Stock.
Северная Америка
Южная Америка
- Venezuela
- Algeria - English
- Armenia - English
- Azerbaijan - English
- Bahrain - English
- Belgium - English
- Belgique - Français
- België - Nederlands
- Česká republika
- Croatia - English
- Cyprus - English
- Danmark
- Georgia - English
- Deutschland
- Eesti
- Egypt - English
- España
- France
- Greece - English
- Iceland - English
- Ireland
Европа, Ближний Восток и Африка
- Israel - English
- Italia
- Jordan - English
- Казахстан
- Kenya - English
- Kuwait - English
- Киргизия
- Latvija
- Lebanon - English
- Lietuva
- Luxembourg - Deutsch
- Luxembourg - English
- Luxembourg - Français
- Mauritius - English
- Moldova - English
- Hungary - English
- Malta - English
- Morocco - English
- Nederland
- Nigeria
- Norge
- Oman - English